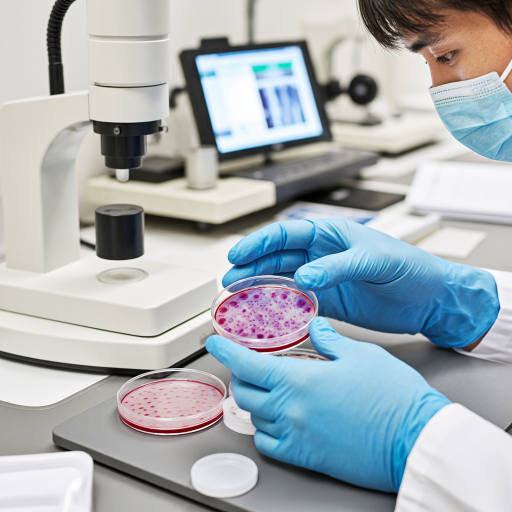

2020年日食发生时间是什么时候?
2020日食发生时间
2020年共发生两次日食事件,分别为一次日环食和一次日全食,具体时间及可见区域如下:
1. 2020年6月21日日环食
- 发生时间:北京时间2020年6月21日14时43分至17时24分(不同地区可见时间略有差异)。
- 可见区域:此次日环食的环食带穿过非洲东部、阿拉伯半岛、巴基斯坦、印度北部、中国南部(包括西藏、四川、贵州、湖南、江西、福建、台湾等地)及太平洋部分区域。中国境内除东北、新疆、内蒙古等极北地区外,大部分地区可观测到日偏食。
- 食分与持续时间:环食阶段最大食分约0.994,环食持续时间最长为38秒(西藏阿里地区附近)。
2. 2020年12月14日日全食
- 发生时间:北京时间2020年12月14日13时33分至17时53分(南美洲局部时区时间不同)。
- 可见区域:此次日全食的全食带仅覆盖南美洲南部,包括智利南部、阿根廷南部及南极洲部分区域。中国境内无法观测到此次日食,仅可通过网络直播或远程观测获取信息。
- 食分与持续时间:全食阶段最大食分约1.025,全食持续时间最长为2分10秒(阿根廷境内)。
观测建议:
- 观测日食需使用专业减光设备(如巴德膜日食眼镜),切勿直接用肉眼或普通墨镜、胶片观看,以免造成永久性视力损伤。
- 若处于日环食或日全食带内,可尝试拍摄日食过程(需加装减光滤镜),但需注意设备参数调整(如降低ISO、缩短曝光时间)。
- 无法亲临现场者,可通过NASA、时间与日期网(Time and Date)等平台查看实时直播或模拟动画。
科普小贴士:
日食发生原理为月球运行至地球与太阳之间,三者几乎成直线时,月球遮挡太阳光形成的天文现象。日环食时月球距离地球较远,无法完全遮盖太阳,形成“火环”效果;日全食时月球距离较近,可完全遮盖太阳盘面。2020年两次日食分别对应这两种类型,且均发生在南半球或低纬度地区,中国境内仅6月21日日环食有部分可见区域。
2020日食具体日期?
2020年全球范围内共发生了两次日食现象,分别是日环食和日全食,以下是具体日期及详细信息:
1. 2020年6月21日(日环食)
此次日环食被称为“金环日食”,是2020年最受关注的天文事件之一。日环食发生时,月球未能完全遮挡太阳,仅遮住中心部分,形成一圈耀眼的“金环”。此次日食的最佳观测区域集中在非洲东部、亚洲南部(包括印度、中国南部、中东地区)以及太平洋部分区域。在中国,西藏、四川、贵州、湖南、江西、福建、台湾等地可观测到日环食,其他地区则可见日偏食。
2. 2020年12月14日(日全食)
此次日全食的可见范围主要在南半球,包括智利、阿根廷的部分地区以及南极洲。日全食发生时,月球完全遮挡太阳,天空短暂变暗,可观测到太阳外层大气(日冕)的壮丽景象。对于身处南美洲南部或南极科考站的人员而言,这是难得的观测机会。其他地区(如南美洲北部、非洲南部)可看到日偏食。
观测注意事项:
- 观测日食需使用专业滤光片或通过投影法间接观看,直接目视可能损伤眼睛。
- 日食时间短暂,需提前查询当地具体时刻表(可参考天文软件如Stellarium或NASA官网)。
- 2020年的两次日食均未覆盖北美洲、欧洲大部及北半球高纬度地区,这些区域的爱好者需等待后续机会。
若需进一步了解某次日食的详细路径或本地观测时间,可补充地理位置信息以便精准查询!
2020日食开始与结束时间?
2020年全球范围内共发生了两次日食现象,分别为一次日环食和一次日全食,以下是具体的时间和可见区域信息:
1. 2020年6月21日日环食
此次日环食是2020年最受关注的天文事件之一,其时间范围如下:
- 开始时间(初亏):北京时间2020年6月21日14时43分(UTC时间06:43)
初亏是指月球开始接触太阳边缘的时刻,此时太阳逐渐被月球遮挡,天色开始变暗。
- 食甚时间:北京时间2020年6月21日16时12分(UTC时间08:12)
食甚是日食过程中太阳被月球遮挡最多的时刻,此时太阳呈现出一个明亮的“火环”,形成日环食的奇观。
- 结束时间(复圆):北京时间2020年6月21日17时31分(UTC时间09:31)
复圆是指月球完全离开太阳表面的时刻,此时太阳恢复完整形态,天色完全变亮。
可见区域:
此次日环食的最佳观测区域位于非洲东部、亚洲南部(包括印度、中国南部、沙特阿拉伯等地)。在中国,西藏、四川、贵州、湖南、江西、福建、台湾等地均可观测到日环食,其他地区可见日偏食。
2. 2020年12月14日日全食
此次日全食是2020年唯一一次日全食,其时间范围如下:
- 开始时间(初亏):北京时间2020年12月14日13时33分(UTC时间05:33)
初亏阶段,月球开始遮挡太阳,天空逐渐变暗。
- 食甚时间:北京时间2020年12月14日15时13分(UTC时间07:13)
食甚时,太阳完全被月球遮挡,形成日全食的“钻石环”或“贝利珠”现象,持续约2分10秒。
- 结束时间(复圆):北京时间2020年12月14日16时53分(UTC时间08:53)
复圆阶段,月球完全离开太阳表面,太阳恢复完整形态。
可见区域:
此次日全食的最佳观测区域位于南美洲南部(包括智利、阿根廷等地)以及南极洲部分区域。其他地区无法直接观测到日全食,但可通过网络直播或科学机构发布的影像资料观看。
观测注意事项:
- 观测日食时,切勿直接用肉眼或普通望远镜观看太阳,需使用专业的日食观测眼镜或通过投影法观测,以免造成视网膜损伤。
- 若在可见区域内,建议提前到达观测点,并关注当地天气情况,选择晴朗无云的时段进行观测。
- 对于无法亲临现场的观众,可通过NASA、ESA等机构官网或天文科普平台观看直播。
总结:
2020年的两次日食分别发生在6月21日(日环食)和12月14日(日全食),时间范围和可见区域如上所述。无论是日环食还是日全食,都是极为罕见的天文奇观,值得天文爱好者关注和记录。
2020日食在哪个地区可见?
2020年的日食中,比较受关注的是2020年6月21日的日环食,也被称为“金环日食”。这次日环食的可见范围覆盖了多个地区,主要集中在亚洲、非洲和欧洲的部分区域。以下是具体可见地区的详细说明:
亚洲地区:
在亚洲,这次日环食的可见范围包括中东地区(如沙特阿拉伯、阿联酋、卡塔尔等)、南亚部分地区(如印度、斯里兰卡)、东南亚部分地区(如印度尼西亚、新加坡)以及中国南部地区(如西藏、四川、贵州、湖南、江西、福建和台湾)。在中国,这次日环食的最佳观测点位于西藏阿里地区,那里可以观赏到接近完美的“金环”景象。非洲地区:
在非洲,日环食的可见范围包括东非部分国家(如埃塞俄比亚、索马里)以及中非和南部非洲的部分地区(如刚果、安哥拉)。这些地区的观测者可以在日食发生时看到太阳被月球遮挡后形成的“光环”。欧洲地区:
在欧洲,日环食的可见范围较为有限,主要集中在东南欧部分地区(如希腊、土耳其)。这些地区的观测者可以在日食发生时体验到部分日食的现象。
如何观测日食?
观测日食时,安全是第一位的。直接用肉眼或普通望远镜观测日食会对眼睛造成严重伤害,甚至导致永久性失明。因此,必须使用专业的日食观测设备,如日食眼镜或带有专用滤镜的望远镜。如果没有专业设备,也可以通过针孔投影法来间接观测日食:用一张带有小孔的纸板将太阳光投影到另一张纸上,从而观察日食的影像。
日食的原理是什么?
日食的发生是由于月球运行到地球和太阳之间,三者几乎成一条直线时,月球遮挡了太阳的光线,使得地球上的部分地区在短时间内看不到太阳或只能看到太阳的部分。日环食是日食的一种特殊形式,当月球距离地球较远时,其视直径小于太阳的视直径,因此无法完全遮挡太阳,从而在月球周围形成一圈明亮的光环。
总结:
2020年6月21日的日环食是一次难得的天文奇观,其可见范围覆盖了亚洲、非洲和欧洲的部分地区。如果你当时位于这些地区,并且有合适的观测设备,那么你一定能够欣赏到这一壮丽的自然景象。即使没有亲临现场,也可以通过网络直播或后续的影像资料来感受日食的魅力。
2020日食持续时间多长?
2020年发生的日食事件中,最受关注的是2020年6月21日的日环食,这也是当年全球范围内可见的主要日食现象。此次日环食的持续时间因观测地点不同而有所差异,但核心的“环食阶段”(即太阳被月球完全遮挡仅剩光环的时段)最长可持续约38秒,具体时间取决于观测者所处的地理位置是否位于环食带的中心路径上。
若从日食的完整过程来看,从初亏(月球开始接触太阳边缘)到复圆(月球完全离开太阳表面),整个日食现象的持续时间通常在2至3小时之间。例如,在中国部分地区观测时,初亏可能发生在上午10点左右,复圆则在下午1点前后,但环食阶段本身仅持续几十秒。这种差异是因为月球的阴影在地球表面移动时,不同地点与阴影中心路径的夹角不同,导致环食的可见时长变化。
对于普通观测者而言,需注意两点:一是环食带的宽度较窄(仅约100公里),仅在此带内的观测者能看到完整的日环食,带外地区可能看到日偏食;二是日食期间必须使用专业日食眼镜或通过投影法观测,直接用肉眼或普通墨镜观看会严重损伤视力。若计划观测,建议提前查询当地的具体时间表,并选择天气晴朗、视野开阔的地点。
此外,2020年还发生过一次日偏食(2020年12月14日),但仅在南美洲部分地区可见,且偏食的持续时间通常比环食更长,但“食分”(被遮挡的太阳比例)较小,视觉效果不如环食显著。因此,当提到“2020日食持续时间”时,通常默认指6月21日的日环食事件。
2020日食最佳观测时间?
2020年发生的日食主要是6月21日的日环食,这是一次非常值得观测的天文现象,下面为你详细介绍此次日食的最佳观测时间以及相关注意事项。
最佳观测时间
此次日环食在中国境内,不同地区的最佳观测时间略有差异。总体来说,从西藏、四川等地开始,日环食会逐渐向东移动。 - 西藏阿里地区:初亏时间大约在6月21日13时10分左右,食既(即开始进入日环食阶段)时间大约在14时45分左右,食甚(日环食达到最大程度)时间大约在14时46分左右,生光(日环食结束)时间大约在14时47分左右,复圆(日环食完全结束,太阳恢复圆形)时间大约在16时29分左右。在这个时间段内,尤其是食既到生光这短短一两分钟,是观测日环食最精彩的时刻,可以看到太阳被月球遮挡后,周围形成一个美丽的光环。 - 四川成都地区:初亏时间大约在6月21日13时47分左右,食既时间大约在15时43分左右,食甚时间大约在15时44分左右,生光时间大约在15时45分左右,复圆时间大约在17时24分左右。同样,食既到生光阶段是观测的关键时段。 - 福建厦门地区:初亏时间大约在6月21日14时43分左右,食既时间大约在16时06分左右,食甚时间大约在16时07分左右,生光时间大约在16时08分左右,复圆时间大约在17时23分左右。
观测前的准备
- 观测设备:如果想要更清晰地观测日食,可以准备专业的日食观测镜。这种观测镜可以有效过滤掉大部分的强光,保护眼睛不受伤害,同时能让你清晰地看到太阳表面的变化。千万不要用普通的墨镜或者自制的滤光片来观测日食,因为它们无法充分过滤掉强光,可能会导致眼睛永久性损伤。如果实在没有专业的日食观测镜,也可以通过小孔成像的方法来间接观测。只需要在一张硬纸板上扎一个小孔,然后让太阳光通过小孔在另一张白纸上成像,这样就可以看到日食的过程。
- 选择观测地点:要选择一个视野开阔、没有遮挡物的地方。比如郊外的山顶、空旷的广场等。避免在高楼大厦之间或者树木茂密的地方观测,以免遮挡视线。同时,要提前了解观测地点的天气情况,选择一个晴朗无云的日子进行观测,否则云层会挡住太阳,影响观测效果。
观测时的注意事项
- 保护眼睛:这是最重要的一点。在整个观测过程中,绝对不能用肉眼直接直视太阳,即使是在日环食的食既到生光阶段,太阳依然非常明亮,直接观看会对眼睛造成不可逆的伤害。一定要使用专业的日食观测镜或者通过小孔成像等安全的方法进行观测。
- 注意时间:要提前查询好当地的日食具体时间,并且提前到达观测地点做好准备。因为日食的过程比较短暂,错过关键时刻可能会留下遗憾。可以在手机上设置好提醒,以免忘记观测时间。
- 记录观测过程:如果有条件的话,可以使用相机或者手机记录下日食的过程。不过在拍摄时,也需要在镜头前加上专业的日食滤镜,否则强烈的阳光可能会损坏相机或者手机的传感器。
总之,2020年6月21日的日环食是一次难得的天文观测机会,只要做好充分的准备,选择合适的观测地点和时间,并且注意保护眼睛,就能安全、清晰地欣赏到这一美丽的天文现象。
2020日食类型是什么?
2020年发生的日食类型主要是日环食哦!这次日环食非常特别,它发生在2020年6月21日,也就是夏至这一天。日环食是一种天文现象,当月球运行到太阳和地球之间,并且三者几乎在同一条直线上时,月球会挡住太阳的大部分光线,但由于月球距离地球较远,看起来比太阳小,所以不能完全遮住太阳,太阳的边缘就会露出来,形成一个光环,这就是日环食啦。
这次日环食的环食带非常宽,从非洲中部开始,经过阿拉伯半岛、巴基斯坦、印度北部、中国南部,一直延伸到太平洋中部。在中国,很多地方都能看到这次日环食的美丽景象,比如西藏、四川、贵州、湖南、江西、福建和台湾等地。在这些地方,人们可以抬头看到太阳被月球遮住后,周围形成的一个明亮的光环,真的非常壮观!

除了日环食,2020年还发生了日偏食。日偏食是日食的一种,当月球只遮住太阳的一部分时,就会发生日偏食。在2020年,除了日环食发生的地区外,其他很多地方都能看到日偏食。虽然日偏食的景象没有日环食那么壮观,但也能看到太阳被月球遮住一部分,天空变暗,气温下降等有趣的现象。
所以,总结一下,2020年发生的日食类型主要是日环食,同时还发生了日偏食。这两种日食都是非常有趣的天文现象,值得我们抬头仰望天空,去感受宇宙的奥秘和美丽!